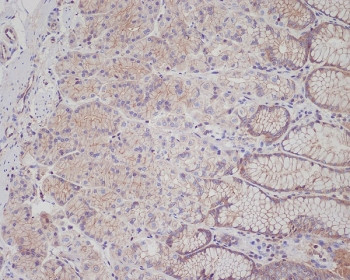
Anti-MET / c-Met / HGFR, clone BFA-13

Cookie preferences
This website uses cookies, which are necessary for the technical operation of the website and are always set. Other cookies, which increase the comfort when using this website, are used for direct advertising or to facilitate interaction with other websites and social networks, are only set with your consent.
Configuration
Technically required
These cookies are necessary for the basic functions of the shop.
"Allow all cookies" cookie
"Decline all cookies" cookie
CSRF token
Cookie preferences
Currency change
Customer-specific caching
FACT-Finder tracking
Individual prices
Selected shop
Session
Comfort functions
These cookies are used to make the shopping experience even more appealing, for example for the recognition of the visitor.
Note
Show the facebook fanpage in the right blod sidebar
Statistics & Tracking
Affiliate program
Conversion and usertracking via Google Tag Manager
Track device being used
| Item number | Size | Datasheet | Manual | SDS | Delivery time | Quantity | Price |
|---|---|---|---|---|---|---|---|
| NSJ-RQ5243 | 100 µl | - | - |
3 - 10 business days* |
790.00€
|
If you have any questions, please use our Contact Form.
You can also order by e-mail: info@biomol.com
Larger quantity required? Request bulk
You can also order by e-mail: info@biomol.com
Larger quantity required? Request bulk
Antibody in PBS with 0.02% sodium azide, 50% glycerol and 0.4-0.5mg/ml BSA. This gene encodes a... more
Product information "Anti-MET / c-Met / HGFR, clone BFA-13"
Antibody in PBS with 0.02% sodium azide, 50% glycerol and 0.4-0.5mg/ml BSA. This gene encodes a member of the receptor tyrosine kinase family of proteins and the product of the proto-oncogene MET. The encoded preproprotein is proteolytically processed to generate alpha and beta subunits that are linked via disulfide bonds to form the mature receptor. Further processing of the beta subunit results in the formation of the M10 peptide, which has been shown to reduce lung fibrosis. Binding of its ligand, hepatocyte growth factor, induces dimerization and activation of the receptor, which plays a role in cellular survival, embryogenesis, and cellular migration and invasion. [RefSeq] Protein function: Receptor tyrosine kinase that transduces signals from the extracellular matrix into the cytoplasm by binding to hepatocyte growth factor/HGF ligand. Regulates many physiological processes including proliferation, scattering, morphogenesis and survival. Ligand binding at the cell surface induces autophosphorylation of MET on its intracellular domain that provides docking sites for downstream signaling molecules. Following activation by ligand, interacts with the PI3-kinase subunit PIK3R1, PLCG1, SRC, GRB2, STAT3 or the adapter GAB1. Recruitment of these downstream effectors by MET leads to the activation of several signaling cascades including the RAS-ERK, PI3 kinase-AKT, or PLCgamma-PKC. The RAS-ERK activation is associated with the morphogenetic effects while PI3K/AKT coordinates prosurvival effects. During embryonic development, MET signaling plays a role in gastrulation, development and migration of neuronal precursors, angiogenesis and kidney formation. During skeletal muscle development, it is crucial for the migration of muscle progenitor cells and for the proliferation of secondary myoblasts. In adults, participates in wound healing as well as organ regeneration and tissue remodeling. Promotes also differentiation and proliferation of hematopoietic cells. May regulate cortical bone osteogenesis. [The UniProt Consortium]
| Keywords: | Anti-MET, Anti-SF receptor, EC=2.7.10.1, Anti-HGF receptor, Anti-HGF/SF receptor, Anti-Proto-oncogene c-Met, Anti-Scatter factor receptor, Anti-Tyrosine-protein kinase Met, Anti-Hepatocyte growth factor receptor, MET Antibody / c-Met / HGFR |
| Supplier: | NSJ Bioreagents |
| Supplier-Nr: | RQ5243 |
Properties
| Application: | IHC (paraffin), WB, IF |
| Antibody Type: | Monoclonal |
| Clone: | BFA-13 |
| Conjugate: | No |
| Host: | Rabbit |
| Species reactivity: | human |
| Immunogen: | A synthetic peptide specific to human c-Met / MET |
| Format: | Purified |
Database Information
| KEGG ID : | K05099 | Matching products |
| UniProt ID : | P08581 | Matching products |
| Gene ID : | GeneID 4233 | Matching products |
Handling & Safety
| Storage: | -20°C |
| Shipping: | -20°C (International: -20°C) |
Caution
Our products are for laboratory research use only: Not for administration to humans!
Our products are for laboratory research use only: Not for administration to humans!
Information about the product reference will follow.
more
You will get a certificate here
Viewed